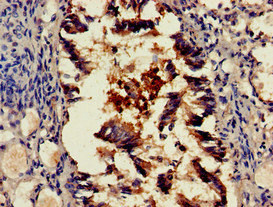

SCTR Antibody
-
中文名稱:SCTR兔多克隆抗體
-
貨號:CSB-PA020865LA01HU
-
規格:¥440
-
圖片:
-
Western Blot
Positive WB detected in: Rat liver tissue
All lanes: SCTR antibody at 2.5µg/ml
Secondary
Goat polyclonal to rabbit IgG at 1/50000 dilution
Predicted band size: 51 kDa
Observed band size: 51 kDa -
Immunohistochemistry of paraffin-embedded human ovarian cancer using CSB-PA020865LA01HU at dilution of 1:100
-
Immunohistochemistry of paraffin-embedded human lung tissue using CSB-PA020865LA01HU at dilution of 1:100
-
Immunofluorescent analysis of PC-3 cells using CSB-PA020865LA01HU at dilution of 1:100 and Alexa Fluor 488-congugated AffiniPure Goat Anti-Rabbit IgG(H+L)
-
-
其他:
產品詳情
-
產品名稱:Rabbit anti-Homo sapiens (Human) SCTR Polyclonal antibody
-
Uniprot No.:
-
基因名:
-
別名:SCTR; Secretin receptor; SCT-R
-
宿主:Rabbit
-
反應種屬:Human, Rat
-
免疫原:Recombinant Human Secretin receptor protein (51-135AA)
-
免疫原種屬:Homo sapiens (Human)
-
標記方式:Non-conjugated
本頁面中的產品,SCTR Antibody (CSB-PA020865LA01HU),的標記方式是Non-conjugated。對于SCTR Antibody,我們還提供其他標記。見下表:
-
克隆類型:Polyclonal
-
抗體亞型:IgG
-
純化方式:>95%, Protein G purified
-
濃度:It differs from different batches. Please contact us to confirm it.
-
保存緩沖液:Preservative: 0.03% Proclin 300
Constituents: 50% Glycerol, 0.01M PBS, pH 7.4 -
產品提供形式:Liquid
-
應用范圍:ELISA, WB, IHC, IF
-
推薦稀釋比:
Application Recommended Dilution WB 1:500-1:5000 IHC 1:20-1:200 IF 1:50-1:200 -
Protocols:
-
儲存條件:Upon receipt, store at -20°C or -80°C. Avoid repeated freeze.
-
貨期:Basically, we can dispatch the products out in 1-3 working days after receiving your orders. Delivery time maybe differs from different purchasing way or location, please kindly consult your local distributors for specific delivery time.
-
用途:For Research Use Only. Not for use in diagnostic or therapeutic procedures.
相關產品
靶點詳情
-
功能:Receptor for secretin (SCT), which is involved in different processes such as regulation of the pH of the duodenal content, food intake and water homeostasis. The activity of this receptor is mediated by G proteins which activate adenylyl cyclase. Upon binding to secretin, regulates the pH of the duodenum by (1) inhibiting the secretion of gastric acid from the parietal cells of the stomach and (2) stimulating the production of bicarbonate (NaHCO(3)) from the ductal cells of the pancreas. In addition to regulating the pH of the duodenal content, plays a central role in diet induced thermogenesis: acts as a non-sympathetic brown fat (BAT) activator mediating prandial thermogenesis, which consequentially induces satiation. Mechanistically, secretin released by the gut after a meal binds to secretin receptor (SCTR) in brown adipocytes, activating brown fat thermogenesis by stimulating lipolysis, which is sensed in the brain and promotes satiation. Also able to stimulate lipolysis in white adipocytes. Also plays an important role in cellular osmoregulation by regulating renal water reabsorption. Also plays a role in the central nervous system: required for synaptic plasticity.
-
基因功能參考文獻:
- elevated in primary sclerosing cholangitis liver samples compared to healthy controls PMID: 27115285
- Structure and Function of Cross-class Complexes of G Protein-coupled Secretin and Angiotensin 1a Receptors. PMID: 27330080
- Cysteine trapping identified charge-charge interactions between secretin and secretin receptor residues in TM5, TM6, ECL2, and ECL3 domains. PMID: 26740626
- Our findings indicate that SCTR suppresses the proliferation of normal breast cells, while the gene stimulates the proliferation and migration of cancer cells being downregulated by promoter methylation. PMID: 26397240
- High SCTR expression is associated with liver metastases of pancreas neuroendocrine tumors. PMID: 25241033
- Results suggest that Secretin is a potent modulator of adipocyte functions, demonstrating overall a role in enhanced substrate cycling. PMID: 22565418
- Taken together, we propose here that the down-regulatory effects of NRSF on hSCTR gene expression are mediated via its suppression on Sp1-mediated transactivation. PMID: 23168245
- results demonstrate that secretin and/or the modulation of SCTR expression might have potential as a therapeutic tool in the treatment of cholangiocarcinoma PMID: 19904746
- Increasing expression of secretin receptor competes for receptor modifying protein 3 (RAMP3) association with calcitonin receptor-like receptor (CLR) to yield a functional adrenomedullin receptor. PMID: 19886671
- promoter methylation plays a role in the regulation of SR gene expression. PMID: 14645499
- Secretin receptor transcripts are present in Purkinje cells and basket cells in the molecular cell layer of human cerebellum. PMID: 15706223
- There is a marked reduction in SCTR binding in ductal neoplasia. PMID: 16192632
- Secretin receptor oligomerization occurs through -GxxxG- motif-independent interactions of transmembrane segments during the maturation of nascent molecules. PMID: 16819820
- The high receptor expression in cholangiocarcinomas may be used for in vivo secretin receptor-targeting of these tumors and for the differential diagnosis with hepatocellular carcinoma. PMID: 16935383
- A novel abnormal spliceoform of the secretin receptor was identified in pancreatic and bile duct cancers and developed as a dual antibody sandwich enzyme-linked immunosorbent assay for measure in the circulation. PMID: 17678920
- Secretin-receptor and secretin-receptor-variant expressions occur in all gastrinomas PMID: 17711922
- secretin receptors are new markers for bronchopulmonary carcinoid tumors PMID: 18223557
- Data show that Family B G-protein-coupled receptor oligomerization occurs, with many structurally related members, such as the secretin receptor,associating with each other. PMID: 18401761
- These results suggest that the secretin receptor can exist only as a structurally-specific homo-dimer, without being present as higher-order oligomers. PMID: 18680717
顯示更多
收起更多
-
亞細胞定位:Cell membrane; Multi-pass membrane protein.
-
蛋白家族:G-protein coupled receptor 2 family
-
數據庫鏈接:
Most popular with customers
-
-
Phospho-YAP1 (S127) Recombinant Monoclonal Antibody
Applications: ELISA, WB, IHC
Species Reactivity: Human
-
-
-
-
-
-